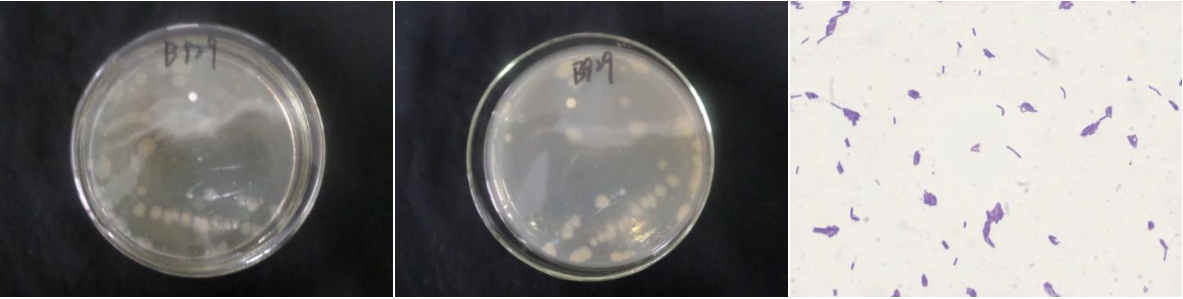

Loading...
| StrainNO | B929 |
| Classification | Falsibacillus |
| 16s rDNA sequence | GTGCCTATACATGCAAGTCGAGCGAATTGATGGGAGCTTGCTCCCTGATATTAGCGGCGGACGGGTGAGTAACACGTGGGTAACC TGCCTGTAAGATTGGGATAACTCCGGGAAACCGGAGCTAATACCGGATAACATGTTGAACTGCATGGTTCAACGTTGAAAGATGG CTTTTAGCTATCACTTACAGATGGACCCGCGGCGCATTAGCTAGTTGGTGAGGTAACGGCTCACCAAGGCGACGATGCGTAGCCG ACCTGAGAGGGTGATCGGCCACACTGGGACTGAGACACGGCCCAGACTCCTACGGGAGGCAGCAGTAGGGAATCTTCCGCAATGG ACGAAAGTCTGACGGAGCAACGCCGCGTGAACGATGAAGGCCTTCGGGTCGTAAAGTTCTGTTGTTAGGGAAGAACAAGTACCAG AGTAACTGCTGGTACCTTGACGGTACCTAACCAGAAAGCCACGGCTAACTACGTGCCAGCAGCCGCGGTAATACGTAGGTGGCAA GCGTTGTCCGGAATTATTGGGCGTAAAGCGCGCGCAGGTGGTTTCTTAAGTCTGATGTGAAAGCCCACGGCTCAACCGTGGAGGG TCATTGGAAACTGGGGAACTTGAGTGCAGAAGAGGAAAGTGGAATTCCAAGTGTAGCGGTGAAATGCGTAGAGATTTGGAGGAAC ACCAGTGGCGAAGGCGACTTTCTGGTCTGTAACTGACACTGAGGCGCGAAAGCGTGGGGAGCGAACAGGATTAGATACCCTGGTA GTYCACGCCGTAAACGATGAGTGCTAAGTGTTAGAGGGTTTTCGCCCTTTAGTGCTGCAGCAAACGCATTAAGCACTTCGCCTGG GGAGTACGGTTGCAAGACTGAAACTCAAAGGAATTGACGGGGGCCCGCACAAGCGGTGGAGCATGTGGTTTAATTTGAAGCAACG CGAAGAACCTTACCAGGTTTTGACATCCTTTGCCACTTTTAGAGATAGAAGGTTTCCCTTCGGGGGACGAAGTGACAGGTGGTGC ATGGTTGTTGTCAGCTTGTGTTGTGAGATGTTGGGTTAAGTTCCGCAACGAGCGCAACCCTTGATTTTAGTTGCCAGCATTCAGT TGGGCCCTTTAAGATGACTGCCGGTGACAAACCGGAGGAAGGTGGGGAAGACGTCAAATCATCATGCCCCTTATGACCTGGGGTA CACACGTGGTACAATGGATGGTACAAAGGGCTGCAAGACTTGGAAATTTAAGGAATTCCCATAAACCCTTTTTCATTTGGGATTC CGGGTTCCAATTCCCTTCCAGGAACCGGGAATCGTTGGTATTCGGGGTTCACCATCCCCCGGGGAATAGGTTCCCGGCCTTTGTC CCCTCCCCCGGCCCCCCCAGGGAATTTGGTACCACCGGAAGTGGTTGGGGTACCCATAAGGAGCCAGCCGCCTAAGGTGACAGTG G |
| Strain Morphology Photos | |
| Morphological Description | Colony round;clam white;edge serrated;Flattened;have concentric rings;multifold;slippy;sticky;Waxed;Rod;having spore;Mesophilic budding spore |